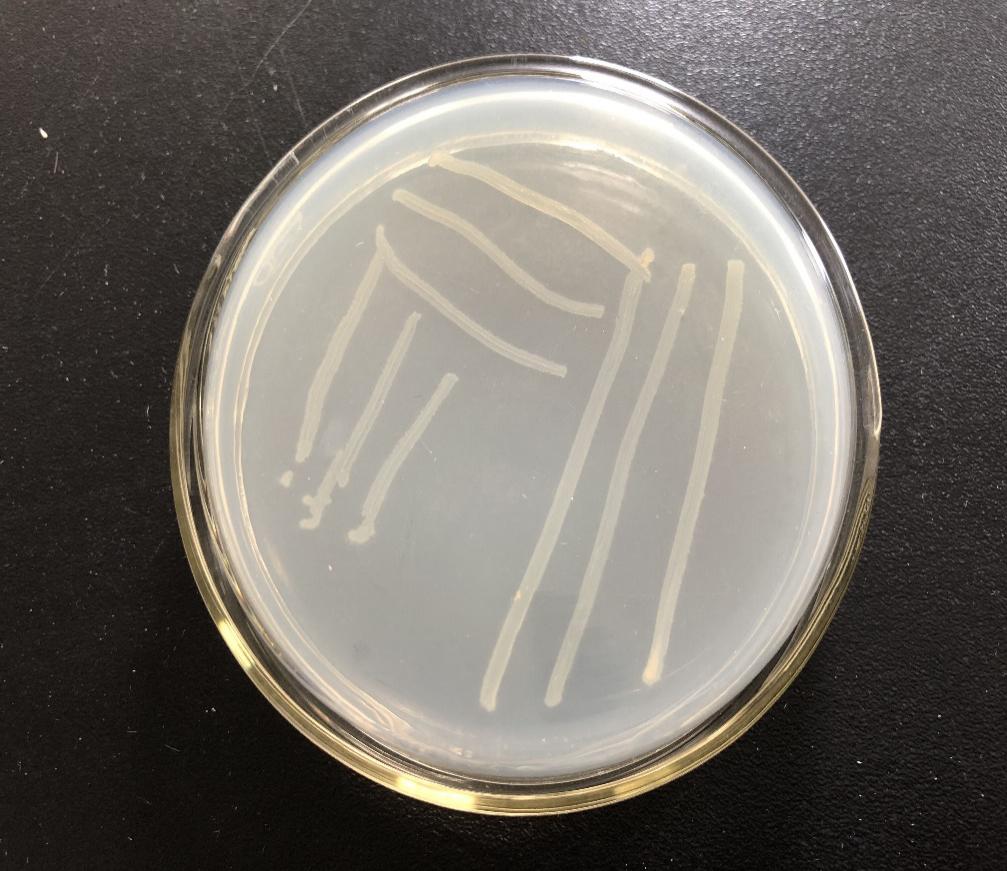

高效苯胺降解菌的筛选、鉴定及降解特性研究毕业论文
2020-04-09 13:59:32
摘 要
苯胺是生产染料、农药和药物化合物的工业化学品,是土壤和地下水中常见的污染物。苯胺被认为是潜在的致癌物质,对人类和水生生物有较大的毒害作用。因其具有生物毒性、且难生物降解而成为废水处理中的一大问题。生物法是目前普遍认为成本较低、无二次污染、处理效果较好的处理苯胺废水的方法。
本文研究了高效苯胺降解菌的筛选、鉴定、生理生态学特性及其降解苯胺的性能。在此基础上,将筛选得到的高效苯胺降解菌投入SBR生物反应器实现快速强化启动。利用高通量测序技术分析了SBR强化系统启动期间微生物群落的丰富度变化和演替规律,并结合反应器启动期间苯胺、COD、NH4 -N、NO3--N和NO2--N等指标的具体变化进行了分析。
研究得出的主要结论如下:
(1)根据苯胺降解效率和细菌生长密度筛选出一株高效苯胺降解菌株,命名为AD1。对菌株AD1进行形态特征观察、生理生化鉴定和16S rRNA全序列系统发育分析,鉴定结果显示菌株AD1属于代尔夫特菌属(Delftia sp.)。
(2)监测了菌株AD1的生长曲线和苯胺降解过程,探究了菌株生长过程中随着苯胺的降解,NH4 -N的释放规律。研究了pH、温度、NH4 -N浓度和苯胺浓度等环境因素对菌株AD1的生长和降解苯胺的影响。
(3)采用投加高效苯胺降解菌株AD1的方式,构建了SBR生物强化反应器,实现了SBR强化反应器在15天内的快速启动,并探究了启动过程中苯胺、COD、NH4 -N、NO3--N和NO2--N等指标的变化规律。
(4)利用高通量测序技术分析了SBR生物强化反应器启动期间微生物群落的演替规律。分别从门、纲和属的水平上分析了各微生物种群的相对丰度变化,以及高效苯胺降解菌AD1在系统中的含量变化。
关键词:苯胺;苯胺降解菌;环境因素;生物强化;高通量测序
Abstract
Aniline is an industrial chemical that produces dyes, pesticides and pharmaceutical compounds and is a common contaminant in soil and groundwater. Aniline is considered a potential carcinogen and has a greater toxic effect on humans and aquatic organisms. Because of its biological toxicity, and difficult to biodegrade, it becomes a major problem in wastewater treatment. The biological method is a method for treating aniline wastewater that is generally considered to have low cost, no secondary pollution, and good treatment effect.
This paper studied the screening, identification, physiological and ecological characteristics of high-efficiency aniline degrading bacteria and their performance in degradation of aniline. On this basis, the high-efficiency aniline degrading bacteria screened out were put into the SBR bioreactor for rapid and enhanced start-up. The high-throughput sequencing technique was used to analyze the changes in the richness and succession of microbial communities during the start-up of the SBR fortification syste. And combined the aniline, COD, NH4 -N, NO3--N, and NO2--N during the start-up of the reactor specific changes were analyzed.
The main conclusions of the study are as follows:
(1) According to the efficiency of aniline degradation and bacterial growth density, a highly efficient aniline-degrading strain was selected and named AD1. The morphological characteristics, physiological and biochemical identification and 16S rRNA sequence analysis of the strain AD1 were performed. The identification results showed that the strain AD1 belonged to Delftia sp.
(2) The growth curve and aniline degradation process of strain AD1 were monitored, and the release of NH4 -N during the growth process of the strain was explored. The influence of environmental factors such as pH, temperature, NH4 -N concentration and aniline concentration on the growth of the strain AD1 and the degradation of aniline were studied.
(3) SBR bio-enhanced reactor was constructed by adding high-efficiency aniline degrading strain AD1, achieving rapid start-up of SBR-reinforced reactor within 15 days, and exploring aniline, COD, NH4 -N, NO3--N ,NO2--N and other indicators during start-up the law of change.
(4) The high-throughput sequencing technology was used to analyze the succession of microbial community during the start-up of SBR bioreactor. The relative abundance changes of various microbial populations were analyzed from the levels of gates, classes, and genera, and the content of high-efficiency aniline degrading bacteria AD1 in the system was analyzed.
Key words: aniline; aniline degrading bacteria; environmental factors; biological enhancement;
high-throughput sequencing
目 录
摘 要 I
Abstract II
第1章 绪论 1
1.1 苯胺的性质、来源及危害 1
1.1.1 苯胺的性质 1
1.1.2 苯胺的来源 1
1.1.3 苯胺的危害 1
1.2 苯胺废水处理技术研究进展 1
1.2.1 物理法 1
1.2.2 化学法 2
1.2.3 生物法 3
1.3 苯胺降解菌的研究进展 3
1.4 SBR的快速启动研究进展 5
1.5 本课题研究内容与意义 6
第2章 实验材料、方法与设计 8
2.1 试验材料及实验装置 8
2.1.1 试验仪器 8
2.1.2 试验装置 8
2.1.3 试验药品 9
2.1.4 培养基 11
2.1.5 污泥与菌种来源 11
2.2 高效苯胺降解菌的分离和筛选 11
2.3 高效苯胺降解菌的鉴定 12
2.3.1 菌株的形态特征 12
2.3.2 生理生化试验 12
2.3.3 16S rRNA序列的测定及系统发育分析 12
2.4 高效苯胺降解菌的生理、生态学特性研究 14
2.4.1 生长曲线 14
2.4.2 影响因子 14
2.5 SBR反应器运行参数 15
2.6 水质分析项目及方法 15
第3章 高效苯胺降解菌的筛选、鉴定及系统发育分析 17
3.1 高效苯胺降解菌的分离和筛选 17
3.1.1 高效苯胺降解菌的分离 17
3.1.2 高效苯胺降解菌的筛选 17
3.2 高效苯胺降解菌的鉴定 19
3.2.1 菌株的形态特征 19
3.2.2 菌株的生理生化鉴定 19
3.2.3 菌株的16S rRNA系统发育分析 20
3.3 本章小结 22
第4章 高效苯胺降解菌的生理、生态学特性研究 23
4.1 生长曲线 23
4.2 代时的计算 24
4.3 苯胺降解与NH4 -N的释放 24
4.4 环境因素的影响 25
4.4.1 pH 25
4.4.2 温度 26
4.4.3 NH4 -N浓度 27
4.4.4 苯胺浓度 28
4.5 本章小结 29
第5章 SBR强化系统的快速启动研究 30
5.1 SBR强化系统的快速启动 30
5.2 SBR强化系统的启动效果 30
5.2.1 苯胺的去除 30
5.2.2 COD的去除 31
5.2.3 氮在苯胺降解过程中的转化 32
5.3 SBR强化系统微生物群落分析 33
5.3.1 微生物多样性分析 33
5.3.2 门水平的细菌分类学分析 36
5.3.3 纲水平的细菌分类学分析 37
5.3.4 属水平的细菌分类学分析 38
5.4 本章小结 39
第6章 结论与建议 40
6.1 结论 40
6.2 建议 41
参考文献 42
致 谢 47
第1章 绪论
1.1 苯胺的性质、来源及危害
1.1.1 苯胺的性质
苯胺,通常也称为氨基苯,分子式为C6H7N,是最常见的胺类物质之一。苯胺是无色或淡黄色透明油状液体,有芳香气味,微溶于水,30℃时苯胺在水中的溶解度为3.7%,可与乙醇,乙醚,氯仿等多种有机溶剂混溶[1]。能随水蒸气挥发,放置于空气中会逐渐变为深棕色。苯胺是一种碱性物质,可与盐酸结合形成盐酸盐,硫酸盐化合成硫酸盐;与酸,卤素,醇,胺剧烈反应并导致燃烧。
1.1.2 苯胺的来源
工业活动的迅速增加导致了含有大量挥发性有机污染物废水的大量排放,而苯胺是制药、染料、香料、橡胶和塑料等各种行业中广泛使用的原料之一[2-3],苯胺及其衍生物也是石油、造纸、煤炭和化学工业的副产品,由其制得的化工产品和中间体有300余种[4]。使用和生产苯胺的工厂都会排放苯胺废水。
1.1.3 苯胺的危害
苯胺是一种能够“致癌、致畸、致突变”的三致物质,对人类和其他生物的健康有很大影响,也会对环境造成严重污染[5]。可经皮肤吸收或经呼吸道吸收,当进入人体血液时,它可以将血红蛋白转化成甲基血红蛋白,阻碍氧气摄取。因此,没有适当处理的苯胺工业废水可能对人类健康和生态系统的平衡构成重大威胁。同时由于苯胺类化合物中含有芳香环的原因导致该分子的生物降解性较差,被列为持久性有机污染物。受到美国环境保护局、欧洲经济委员会等许多世界上其他组织越来越多的关注[6]。
1.2 苯胺废水处理技术研究进展
目前,国内外常用的处理苯胺废水的方法主要有物理法、化学法和生物法。
1.2.1 物理法
物理方法包括吸附法,萃取法和膜分离法,是利用吸附、萃取和渗透等物理过程将苯胺从废水中分离出来的方法,不会改变苯胺的结构和性质。吸附法是一种用多孔吸附材料处理苯胺废水的方法。吸附法虽然操作比较简单,但是吸附剂存在吸附容量,当吸附苯胺的量达到平衡时,就要更换吸附剂,需要一定的成本。萃取法使用与水不混溶但能够溶解苯胺的萃取剂,以便与含苯胺废水充分混合,利用苯胺在水和溶剂中的溶解度不同来分离和提取苯胺。萃取法的优点主要是工艺设备比较简单,缺点是萃取过程中使用的有机溶剂会对环境造成二次污染[7]。膜分离是使用特殊的半透膜将苯胺渗透以达到分离的目的。虽然这种方法对苯胺废水有很好的处理效果,但由于需要定期清洗,成本高,而且产生的浓缩废水处理难度较大,还需进一步研究。
1.2.2 化学法
(1)光催化氧化是利用光催化剂如二氧化钛通过光催化氧化苯胺生成二氧化碳,水和一些简单无毒的小分子无机物。Chen[8]等通过简单的沉积方法从水溶液中制备MgO作为催化剂,在有氧的光照条件下进行光催化反应,将苯胺氧化为亚硝基苯,实现了苯胺废水的再次利用。光催化氧化只需要光,催化剂和空气[9],加工成本相对较低。
(2)电催化氧化分为直接氧化和间接氧化。直接氧化是直接通过阳极反应降解苯胺;间接氧化通过阳极反应产生羟基自由基(HO·)和臭氧,并利用阳极反应产物的高氧化活性使苯胺部分矿化,生成小分子有机或无机物[10]。电催化氧化法具有较强的氧化能力,苯胺降解的更彻底,基本上没有有毒的中间体,更加环保。
(3)超临界氧化法以水为介质,在超临界条件(T gt;374℃,P gt;22 .1 MPa)下将苯胺完全氧化[11]。何磊[12]利用超临界水氧化技术处理COD为5350 mg/L的高浓度苯胺废水,对COD的降解效率达到了96%,对苯胺的去除十分彻底。由于在超临界条件下气-液界面没有传质阻力,所以超临界氧化法具有反应速度快,反应时间短的特点。
(4)二氧化氯氧化法是利用二氧化氯的强氧化性将苯胺氧化降解。Xie[13]等使用二氧化氯氧化苯胺,探究了该反应的最佳条件为:pH 5.8,温度35 ℃,苯胺与二氧化氯的浓度之比为3∶10时,30 min 内对浓度为20-50 mg/L苯胺的去除率达到73.26%。 该方法适用于处理苯胺浓度较低的废水,主要特点是二氧化氯氧化能力强反应彻底、氧化过程不产生有毒有害物质[14]。
(5)超声波法降解水中的苯胺是一种新型深度氧化技术。、、等强氧化性物质直接或间接作用于废水中的有机污染物[15]。同时,产生的声空化气泡具有促进光电子产生,加速传质和激活催化剂表面的功能[16]。可以与其他方法结合使用,以更高效和彻底地降解废水中的有机污染物。
总的来说,化学法是利用强氧化剂或者某些途径将苯胺氧化,生成小分子物质或者无机物达到苯胺的去除。化学法去除苯胺比较彻底,但是有时候会受到特定条件或者氧化剂不稳定等情况的影响。
1.2.3 生物法
生物法主要是利用微生物的生长代谢作用来降解废水中的苯胺。与其他方法相比,生物方法具有无二次污染,成本效益高等优点[17-18]。由于苯胺对微生物有一定的毒性,传统的生物法只能处理浓度较低的苯胺废水[19]。采用传统的生物法处理效果并不理想,需对工艺进行改进或者培育高效苯胺降解菌种。
O’Neill[20]等利用固定膜生物反应器探究了好氧、发酵、硝酸盐还原、硫酸盐还原、不同盐浓度和pH值等条件下细菌对苯胺的降解。发现盐度、pH在一定范围内变化,会使反应器里面的菌体生长延迟期增长,但依然能保持其降解苯胺的能力,没有获得能够在发酵、硝酸盐还原和硫酸盐还原条件下降解苯胺的微生物。
古杏红[21]等采用厌氧水解-生物接触氧化工艺处理苯胺废水,并在生物接触氧化池中接种苯胺降解菌。在厌氧水解段将大分子有机物转化为易被利用的小分子有机物,提高了污水的可生化性,厌氧水解段出水进入生物接触氧化池,苯胺由专性苯胺降解菌进行降解。该工艺对COD和苯胺的去除率分别为85.9 %和 97.8 %,出水达到了一级排放标准。
Zhang[22]等使用黑曲霉菌丝团作为生物载体固定苯胺降解菌(醋酸钙不动杆菌 JH-9)和COD快速降解菌的混合培养物,将组合的菌丝体颗粒投加到SBR中,研究其对苯胺和COD的去除效果,并与只接种苯胺降解菌的另一个SBR反应器进行比较。结果表明,两个反应器中的苯胺和COD都能被稳定降解。在菌丝团固定菌种的SBR中,去除率约为0.9 毫克苯胺/(L·d),要比活性污泥反应器的去除率高很多。同时发现固定在菌丝团载体上的物种在该系统中更占优势,是因为生物载体为菌株提供了稳定的生活环境,使菌株能更好地在系统中生长并发挥降解苯胺的作用。
以上是毕业论文大纲或资料介绍,该课题完整毕业论文、开题报告、任务书、程序设计、图纸设计等资料请添加微信获取,微信号:bysjorg。
相关图片展示: